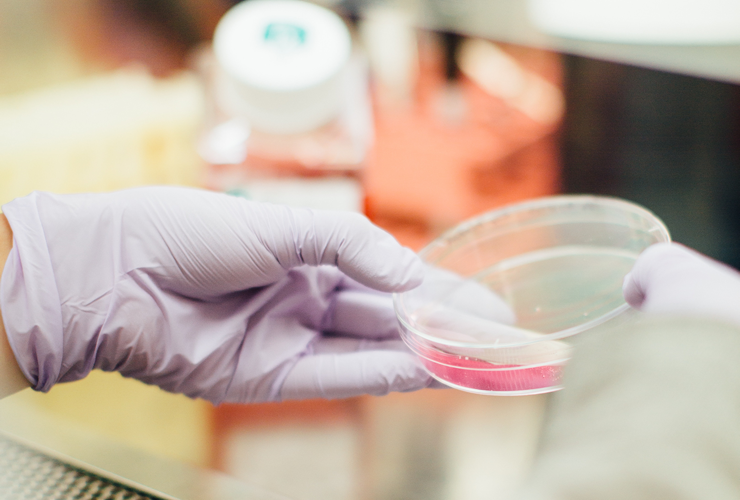
big pharma 2 hero

What does AI really mean for big pharma?
Add bookmarkArtificial intelligence could herald a new era for drug development but caution remains about how revolutionary its impact will actually be

Photo by Elizabeth Misner on Unsplash
GlaxoSmithKline’s $43m deal with British AI firm Exscientia may signal a revolution for drug development that could radically speed up the drug discovery process, helping patients in urgent need of specialist treatments.
Other leading pharma giants—including Johnson & Johnson and Merck—are also looking at investments in the AI sphere on the expectation that AI platforms are poised to reshape the pharma industry.
In the same way that the financial industry has employed physicists and mathematicians to develop predictive software to fine-tune trading decisions, many experts predict that pharma industry will be particularly receptive to AI solutions because of its inherent grounding in science and innovation.
AI is poised to become “the primary drug discovery tool by 2027,” according to AstraZeneca’s Global Head of Enterprise Architecture.
But new artificial intelligence technologies remain ostensibly unproven in the field of pharma research and despite the hype and excitement it could yet take many years before patients reap the benefits.
The discovery challenge
The meticulous nature of pharma research and development means that drug discovery—taking a new pharmaceutical drug to market once a lead compound has been identified—can take more than a decade.
The development of a single drug can often cost more than $1bn because of inefficiencies in the sampling process and the vast number of screenings that are typically required; fewer than one in ten drugs that enter the discovery process actually end up being taken to market.
GSK hopes the Exscientia deal will allow it to use AI technology to isolate hard-to-find molecules in the drug discovery process to help speed up the development of treatments in a number of targeted areas. It could result in significantly shorter development times, and reduced costs, because screenings will be largely replaced by supercomputer simulations and predictive algorithms.
Read more: The benefits that a digital healthcare system could bring aren't out of reach
Exscientia’s deep learning systems look to balance the potency and selectiveness of a new drug with its pharmacokinetics—the speed at which the drug can pass through a human body. The Dundee-based company’s AI technologies have already attracted investment from a number of pharma groups including Germany’s Evotec (immuno-oncology), France’s Sanofi (metabolic diseases), and Japan’s Sumitomo Dainippon Pharma (central nervous system disorders).
Andrew Hopkins, CEO at Exscientia, said the company’s AI-driven platform has the potential to accelerate the discovery of novel, high-quality drug candidates.
“Applying our approach to client discovery projects has already delivered candidate-quality molecules in roughly one-quarter of the time, and at one-quarter of the cost of traditional approaches,” he said.
Clinical stages could benefit from AI technology in regards to trial design, site selection and patient enrolment. Adverse events and diagnostic testing can be better forecasted with the help of artificial intelligence. Machine learning and analytics can speed up the examination of clinical trial data for example with marker identification. This software could also advance pharmacovigilance measures, further down the drug discovery process.
Healthcare impact
The pharma industry has already been experimenting with AI technology for a couple of years in the field of cancer research. IBM Watson—the supercomputer that combines artificial intelligence and sophisticated analytical software—has been used since 2015 to help develop breast cancer treatments and AI start-ups like BenevolentAI, Atomwise and Berg have secured contracts in this area.
Moreover, AI could also disrupt the marketing, sales, customer-care and interaction processes within the wider healthcare market, as well as the drug development process.
Photo by Drew Hays on Unsplash
The healthcare industry has long relied on staff-heavy business model: employing armies of sales staff to engage with various levels of medical staff to encourage the adoption of its latest drugs.
AI technologies have, however, opened the door to automatic data-gathering, monitoring and diagnostic feedback from patients. It means pharma companies may soon find themselves under pressure to sell full packages of treatment services rather than just individual drugs.
Healthcare organisations have also adapted intelligent consumer products to increase efficiency. Boston Children's Hospital has, for example, augmented Amazon Echo’s Alexa assistant to give parents health advice about their child's symptoms, medication dosage and when to call a doctor.
Pharma companies may soon find themselves under pressure to sell full packages of treatment services rather than just individual drugs.
Even more ambitious AI experimentation is being undertaken to push health research to ground-breaking limits. German biotech company InSilico is using Deep Neural Networks (DNNs) to reduce the effects of aging by identifying—and ultimately altering—the individual biomarkers that influence when and how we will die.
Uncertainties remain
Despite the excitement these innovations have elicited, there remains a lot of scepticism in the healthcare industry—built as it is on clinical trials and evidence-based reasoning—about how much influence AI could actually have over the medium and even longer term.
The benefits of AI investment in healthcare have yet to be proven. At present, no AI-based process has yet brought a new molecule from inception to market; a process that currently takes on average of at least five years.
The promises of “disruptive technologies” have failed to live up to expectations in the past. For example, the development of ‘high throughput screening’—a process that employs robotics to conduct millions of chemical, genetic and pharmacological tests in rapid time—in the 1990s failed to significantly reduce R&D inefficiencies and offered sporadic success rates.
“The major cost in drug R&D is last-phase clinical trials,” said Dr Mark Gerstein, professor of biomedical informatics at Yale University. “It is not clear whether AI can be as useful for these as it has been in target selection for the initial phases.”
“One of the first principles of data mining is that history is a good predictor of the future. AI has a track record of not living up to its expectations and therefore caution about how great its impact will be in the healthcare industry is now warranted.”
Want more? Become a member of the AI & Intelligent Automation Network for free access to industry news, whitepapers and articles. Sign up today.